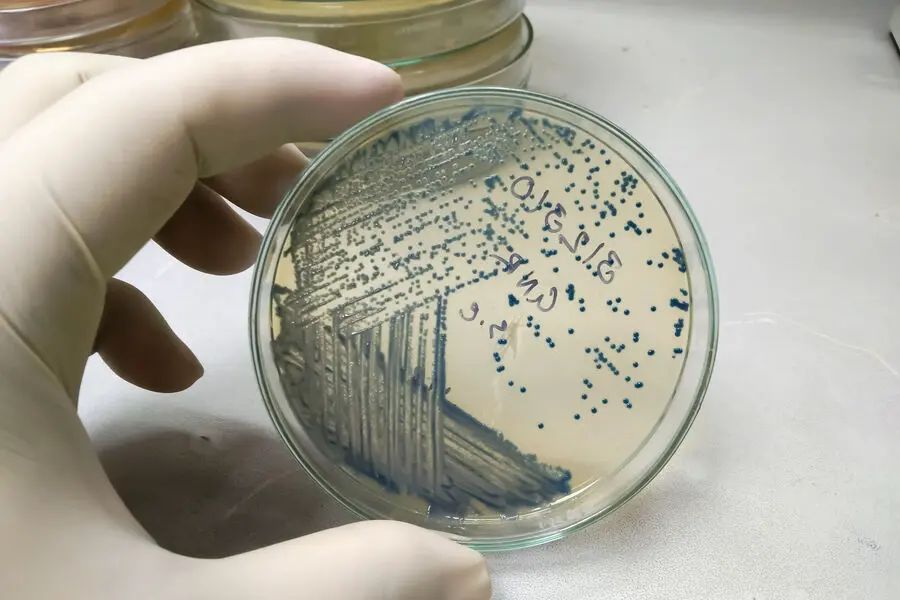

Современная наука стремительно развивает новые методы для решения актуальных задач человечества. Исследователи из Университета Нагоя совместно с коллегами из Национального института передовых промышленных наук и технологий, а также Университета Васэда сделали большой шаг вперед в области биотехнологий с использованием бактерии Escherichia coli. Их инновационный подход к получению белков открывает перспективы для зелёных технологий и нового поколения экологически чистого производства.
Эволюция биосинтеза: новые взгляды на применение Escherichia coli
Микроорганизмы типа Escherichia coli давно зарекомендовали себя как ценные «фабрики» для производства широчайшего спектра биомолекул. От лекарств и пищевых ферментов до диагностических средств, биотоплива и биопластика — белки, синтезируемые такими микробами, всё активнее находят применение в различных отраслях. Повышение эффективности этих биопроцессов является важнейшей целью, ведь с их помощью можно сократить углеродный след и снизить зависимость промышленности от нефти и газа.
Проблемы и решения в синтезе белков
Одной из главных преград на пути к увеличению выхода белков является феномен «остановки рибосом» — когда специализированные молекулярные комплексы в клетке могут внезапно прекратить участие в сборке белка по инструкции РНК. Это снижает продуктивность биосистем. Ученые выяснили, что если добавить к началу белковой цепи короткую последовательность из четырех аминокислот — серина, лизина, изолейцина и лизина — рибосомы значительно реже прекращают работать. Этот нехитрый, но эффективный прием открывает возможность усовершенствовать процесс трансляции (процесс создания белков) и тем самым добиться высокого выхода ценных биопродуктов.
Искусственный интеллект в поиске эффективных пептидов
Для дальнейшего развития методики команда ученых совместно с японскими партнерами сформировала обширную библиотеку тетрапептидов — коротких последовательностей из четырех аминокислот. В нее вошли 160 000 уникальных комбинаций, охватывающих весь спектр потенциально возможных последовательностей из двадцати естественных аминокислот. Чтобы выбрать лучшие из них, исследователи задействовали искусственный интеллект. Модель была обучена на данных сотен экспериментов, что позволило ей эффективно прогнозировать, какие из пептидов существенно увеличивают синтез необходимых белков. Трехкратная проверка данных подтвердила точность прогноза, а найденные последовательности были включены в новый атлас «трансляционно-усиливающих пептидов».
Промышленность будущего: быстрые, доступные и экологичные решения
Технология, основанная на новых коротких пептидах, имеет потенциал революционизировать производство биопродуктов. Она позволяет не только усиливать синтез белков в бактериях, но и применять интеллектуальные алгоритмы для автоматического выбора идеальных последовательностей под задачи конкретного производства. В результате появляется возможность повысить эффективность выпуска промышленных ферментов, которые являются основой таких направлений, как производство биотоплива или биоразлагаемых пластиков.
Вклад японской науки в устойчивое развитие
Новый подход, возникший на стыке молекулярной биологии, синтетической биологии и искусственного интеллекта, способствует созданию «умных» систем биосинтеза. Такие решения помогут промышленным компаниям запускать экологически чистые процессы, сокращать издержки и предлагать продукцию с минимальным воздействием на окружающую среду. Команда исследователей из Университета Нагоя, Национального института передовых промышленных наук и технологий и Университета Васэда доказывает, что даже давно известные микроорганизмы, такие как Escherichia coli, могут сыграть ключевую роль в построении устойчивого, «зеленого» будущего. Их работа вдохновляет на дальнейшие инновации и дает надежду на то, что биотехнологии совсем скоро станут основой здоровой планеты и стабильной экономики.
Источник: www.gazeta.ru/






